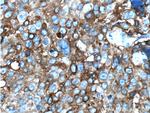
MAGEA3 Antibody in Immunohistochemistry (Paraffin) (IHC (P))
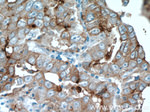
MAGEA3 Antibody in Immunohistochemistry (Paraffin) (IHC (P))
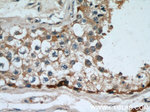
MAGEA3 Antibody in Immunohistochemistry (Paraffin) (IHC (P))

Search
Proteintech
MAGEA3 Monoclonal Antibody (1A9F3)
{{$productOrderCtrl.translations['antibody.pdp.commerceCard.promotion.promotions']}}
{{$productOrderCtrl.translations['antibody.pdp.commerceCard.promotion.viewpromo']}}
{{$productOrderCtrl.translations['antibody.pdp.commerceCard.promotion.promocode']}}: {{promo.promoCode}} {{promo.promoTitle}} {{promo.promoDescription}}. {{$productOrderCtrl.translations['antibody.pdp.commerceCard.promotion.learnmore']}}
产品信息
60054-1-IG
种属反应
宿主/亚型
分类
类型
克隆号
抗原
偶联物
形式
浓度
规格
纯化类型
保存液
内含物
保存条件
运输条件
产品详细信息
Immunogen sequence: MPLEQRSQH CKPEEGLEAR GEALGLVGAQ APATEEQEAA SSSSTLVEVT LGEVPAAESP DPPQSPQGAS SLPTTMNYPL WSQSYEDSSN QEEEGPSTFP DLESEFQAAL SRKVAELVHF LLLKYRAREP VTKAEMLGSV VGNWQYFFPV IFSKASSSLQ LVFGIELMEV DPIGHLYIFA TCLGLSYDGL LGDNQIMPKA GLLIIVLAII AREGDCAPEE KIWEELSVLE (1-229 aa encoded by BC000340)
靶标信息
This gene is a member of the MAGEA gene family. The members of this family encode proteins with 50 to 80% sequence identity to each other. The promoters and first exons of the MAGEA genes show considerable variability, suggesting that the existence of this gene family enables the same function to be expressed under different transcriptional controls. The MAGEA genes are clustered at chromosomal location Xq28. They have been implicated in some hereditary disorders, such as dyskeratosis congenita.
仅用于科研。不用于诊断过程。未经明确授权不得转售。
生物信息学
蛋白别名: Antigen MZ2-D; Cancer/testis antigen 1.3; cancer/testis antigen family 1, member 3; CT1.3; MAGE-3 antigen; MAGEA3; MAGEA6; melanoma antigen family A, 3; melanoma antigen family A3; Melanoma-associated antigen 3; MGC14613; unnamed protein product
基因别名: CT1.3; HIP8; HYPD; Mage-a3; MAGE3; MAGEA3; MAGEA6
UniProt ID: (Human) P43357
Entrez Gene ID: (Human) 4102, (Mouse) 17139